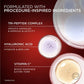
L'Oreal Paris Revitalift Triple Power 3% Peptides Serum 1 fl oz - Imperfect Box

1
/
de
8
L'Oreal Paris Revitalift Triple Power 3% Peptides Serum 1 fl oz
Imperfect Box 

This item is new, but the box has some damage. Nothing to worry about as the product inside remains unharmed.
L'Oreal Paris Revitalift Triple Power 3% Peptides Serum 1 fl oz - Imperfect Box
Preço normal
$10.95
Preço de saldo
$10.95
Preço normal
Was
$19.99
Preço unitário
/
por
Preço de saldo
Save $9.04 (45% off)
Envio calculado na finalização da compra.
WE SHIP WORLDWIDE
Não foi possível carregar a disponibilidade de recolha
Buy any 2 items | Get 10% off |
Buy any 3 items | Get 15% off |
Buy 4 or more items | Get 20% Off |
Free shipping on all orders over $30
Free shipping on all orders over $30
Get free shipping on all orders over $30. Consider adding more to your basket to take advantage of this offer.
Authenticity and quality guaranteed
Authenticity and quality guaranteed
We only partner with trusted retailers and brands with full traceability back to the manufacturing source. All of our products have their authenticity guaranteed and are put through our rigorous 6-point quality control process.
Shop sustainably with This is Beauty
Shop sustainably with This is Beauty
Every product you purchase from This is Beauty helps reduce the environmental impact of the beauty industry. Just because there is an imperfection doesn’t mean the product should end up in landfill. What's inside is perfect!
Revitalift Triple Power Age-Defying Serum is a potent 3-in-1 serum for face that excels at reducing wrinkles, firming, and brightening. Our formula combines an innovative blend of ingredients for visible, age-defying results:
Tri-Peptides (3% Matrixyl 3000 known to improve the feel of skin's elasticity, Argireline Amplified Peptide, known to help smooth the look of wrinkles, and Carnosine, known for its antioxidant properties)
Hyaluronic Acid serum to hydrate and plump, a key component of this effective hydrating serum.
Vitamin C to boost radiance and even tone, making this a powerful vitamin c serum face.
Immediately, skin feels hydrated and looks smoother with this incredible skin serum. Overtime, it noticeably reduces wrinkles, firms, brightens, and plumps. This makes it an ideal anti aging serum for your skincare routine. Derm-tested, paraben-free, mineral-oil free, non-greasy, and fast-absorbing, our formula is effective for all skin types, even sensitive.
Every morning and evening after cleansing, apply 3 to 4 drops of this transformative serum vitamin c to your face and neck. Massage until well absorbed. Follow with your usual moisturizer and AM sunscreen.
Frequently Asked Questions about Revitalift Triple Power Age-Defying Serum
What are the primary benefits of the Revitalift Triple Power Age-Defying Serum? This 3-in-1 serum is designed to visibly reduce wrinkles, firm your skin, and boost overall brightness. It provides immediate hydration and smoothing, with continued use leading to significant improvements in wrinkle reduction, firmness, even tone, and plumpness, making it a comprehensive solution for age-defying skin care.
What are the key ingredients in this serum and what do they do? Our advanced formula features a powerful blend of ingredients:
Tri-Peptides: This complex includes 3% Matrixyl 3000 to improve skin's elasticity, Argireline Amplified Peptide to help smooth the look of wrinkles, and Carnosine for its antioxidant properties.
Hyaluronic Acid: Known for its incredible hydrating capabilities, Hyaluronic Acid deeply moisturizes and plumps the skin, giving it a fuller, more youthful appearance.
Vitamin C: A renowned antioxidant, Vitamin C boosts skin's radiance and helps to even out skin tone for a brighter complexion.
How do I incorporate the Revitalift Triple Power Age-Defying Serum into my daily skincare routine? For optimal results, apply 3 to 4 drops of the serum to your face and neck every morning and evening after cleansing. Gently massage the serum until it is well absorbed into your skin. Always follow up with your usual moisturizer, and remember to apply sunscreen in the morning.
How quickly can I expect to see results from using this serum? You will notice immediate benefits with this serum, as your skin will feel hydrated and look smoother right after the first application. With consistent, continued use, you can expect to see significant visible improvements over time, including reduced wrinkles, firmer skin, more even tone, and a plumper complexion.
Is this serum suitable for all skin types, including sensitive skin? Yes, the Revitalift Triple Power Age-Defying Serum is formulated to be effective for all skin types, including sensitive skin. It is derm-tested, paraben-free, mineral-oil free, non-greasy, and fast-absorbing, ensuring a gentle yet powerful experience.
What is the texture of the serum? The serum has a lightweight, non-greasy, and fast-absorbing texture, allowing it to penetrate quickly without leaving any sticky residue, making it comfortable for daily use under other products.








-
ACCESSIBILITY
Shop NowYour favorite brands and products at accessible prices, with quirks and imperfections and their own story to tell.
-
SUSTAINABILITY
About UsCombating unnecessary waste in the beauty industry by purchasing perfectly good products to keep them in circulation for longer.
-
COMMUNITY
TIB BlogWe’re a movement. A community. A conversation. We’re working with you to have hard conversations and change from the inside out.